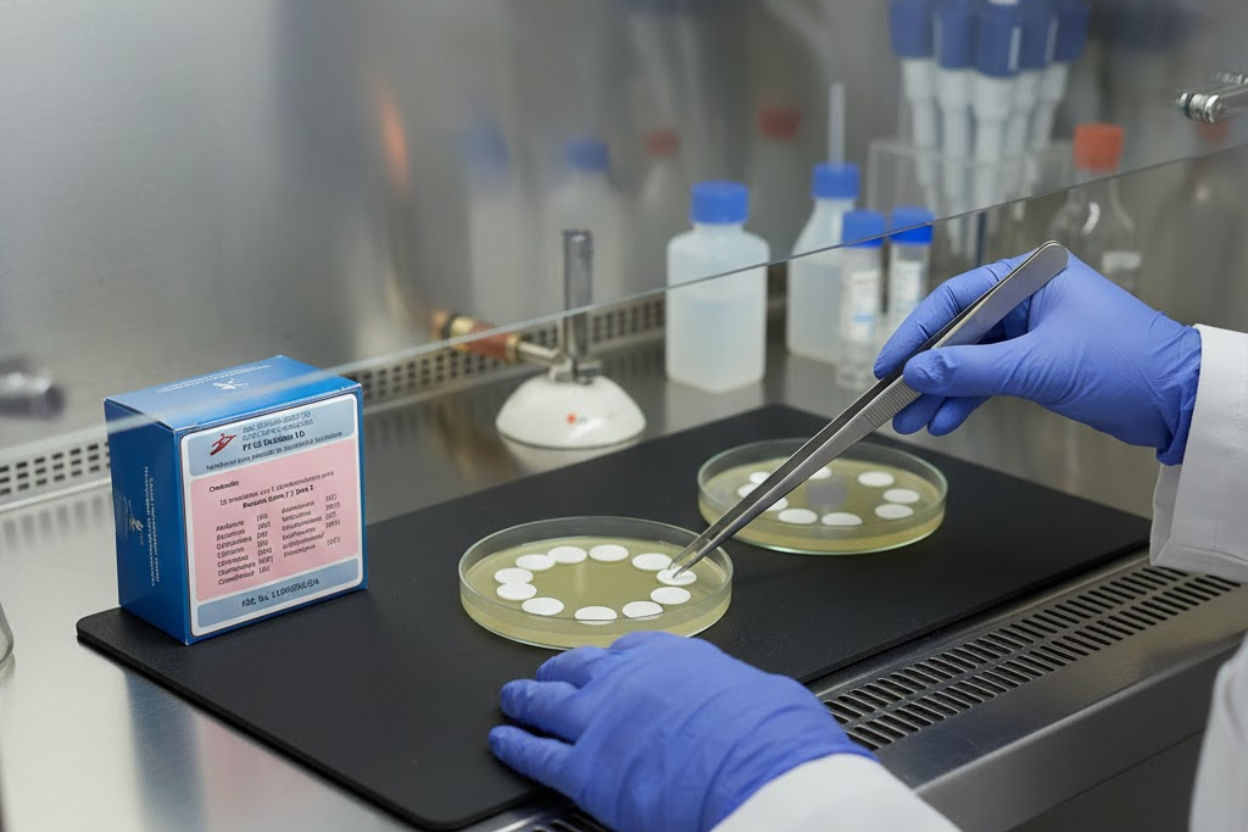

TOMA DE MUESTRA
Sistema S-Monovette® 2en 1 de Sarstedt.
Redefine la toma de muestra combinando seguridad, precisión y comodidad en un solo dispositivo. Gracias a su innovadora tecnología que permite trabajar en modo al vacío o en modo aspiración, garantiza una extracción perfectamente adaptada a cada paciente, incluso a aquellos con venas frágiles o difíciles.

Química Clínica

ARCHITECT c4000
Precisión y productividad que transforman tu laboratorio Optimiza cada paso del análisis clínico con el ARCHITECT c4000, el analizador de química clínica automatizado de Abbott diseñado para ofrecer resultados confiables y rápidos. Ideal para laboratorios con alto volumen de muestras, el c4000 combina alta productividad, precisión y flexibilidad, respaldando decisiones médicas seguras desde la primera muestra.

HEMATOLOGÍA

CELL DYN Emerald
Hematología compacta, resultados confiables Descubre la eficacia de la hematología moderna con CELL DYN Emerald — el analizador compacto de Abbott diseñado para laboratorios clínicos pequeños o medianos que buscan rapidez, fiabilidad y simplicidad. Gracias a su tecnología avanzada, ofrece resultados precisos en apenas ~60 segundos por muestra, con parámetros completos que incluyen conteo de glóbulos blancos, rojos, plaquetas, hemoglobina y más.

HumaCount 5D / HumaCount 80TS /
HumaCount 30TS
Ofrece una completa gama de analizadores y sistemas de hematología diseñados para adaptarse a las necesidades de laboratorios de cualquier tamaño. Nuestra línea de hemogramas automatizados procesa entre 30 y 80 muestras por hora e incluye sistemas diferenciales de 3 y 5 partes, con reactivos específicos para aplicaciones humanas.
COAGULACIÓN

STA Compact Max® / STart Max®
Soluciones completas en coagulación y hemostasia, diseñadas para laboratorios clínicos, hospitales y bancos de sangre que buscan precisión, confiabilidad y eficiencia. Su línea incluye analizadores semi y automatizados, junto con reactivos y controles, que permiten realizar desde pruebas rutinarias hasta estudios especializados con resultados rápidos y consistentes.

HumaClot Junior | Duo Plus | Quattro
Una familia de analizadores de coagulación semiautomatizados
Los instrumentos de hemostasia semiautomatizados de HUMAN ofrecen el equilibrio perfecto entre fiabilidad, exactitud y facilidad de uso. Diseñados para laboratorios pequeños y medianos, proporcionan un rendimiento excepcional sin los altos costos ni la complejidad de los sistemas totalmente automatizados.
HEMOGLOBINA

HumaNex A1c Variant
Sistema HPLC para la medición a pequeña y mediana escala de la hemoglobina glicosilada HbA1c
Mejor el diagnóstico y seguimiento de pacientes diabéticos al ofrecer una solución ideal para laboratorios con volúmenes pequeños y medianos de pruebas de HbA1c, incorporando además la detección de variantes. Forma parte de la completa cartera de HUMAN para el manejo integral de la diabetes, que cubre desde el diagnóstico inicial hasta el control terapéutico y la medición diaria de glucosa.
INMUNOLOGÍA

ARCHITECT i1000SR
Ofrece resultados rápidos, confiables y consistentes, ideal para laboratorios de volumen bajo o medio. Con capacidad de hasta 100 pruebas por hora, tecnología avanzada CHEMIFLEX y manejo automatizado de muestras, permite realizar inmunoensayos de hormonas, serología, marcadores tumorales y más.

GASOMETRÍA

El sistema de análisis de sangre epoc® transforma la atención clínica al ofrecer resultados de calidad de laboratorio en el punto de atención. Esta solución inalámbrica y portátil permite realizar pruebas integrales al lado del paciente, con tarjetas almacenadas a temperatura ambiente y resultados en menos de un minuto, agilizando la toma de decisiones, optimizando el flujo de trabajo, simplificando el inventario y proporcionando resultados e informes en tiempo real.
BACTERIOLOGÍA/
INMUNOLOGÍA
IDLAB brinda soluciones integrales en diagnóstico clínico, ofreciendo un portafolio robusto de reactivos, kits y equipos que permiten a laboratorios, hospitales y centros de salud realizar exámenes confiables, precisos y conformes a normativas vigentes.
Gama de productos:
- Reactivos y kits para bacteriología: medios de cultivo, hemocultivos (adulto y pediátrico), identificación microbiana, paneles de sensibilidad antimicrobiana para bacterias Gram positivas y Gram negativas.
- Diagnóstico serológico e inmunológico: reactivos y pruebas especializadas para la detección de antígenos, pruebas reumáticas, pruebas de sífilis, pruebas de reaginas, proteínas como proteína C reactiva, factor reumatoide, entre otros.
- Control de calidad y reactivos especializados.
SOFTWARE

El sistema está diseñado para la administración y operación del Laboratorio Clínico, brindando al usuario una interfaz amigable e intuitiva y de fácil configuración, garantiza la fiabilidad de los resultados gracias a las interfaces entre el sistema y los analizadores, cuenta con una interfaz web para la consulta de resultados tanto de pacientes, médicos y empresas.

RED FRÍA

Soluciones especializadas de red fría para laboratorio clínico que garantizan la correcta conservación y seguridad de reactivos, muestras biológicas y controles, asegurando estabilidad térmica, trazabilidad y el cumplimiento de la normatividad vigente aplicable a laboratorios clínicos.
Equipamiento disponible:
- Refrigerador para reactivos.
- Refrigeradores para Vacunas.
- Congelador / Ultracongelador.
- Cajas de transporte pasivas.
- Cajas de transporte para Vacunas.
- Datalogger
Nuestras soluciones están diseñadas para adaptarse a las necesidades operativas del laboratorio clínico, garantizando conservación segura, monitoreo continuo y respaldo operativo confiable.
Equipos Complemento
-
Cantrífugas. – Microscopios – Micropipietas.



